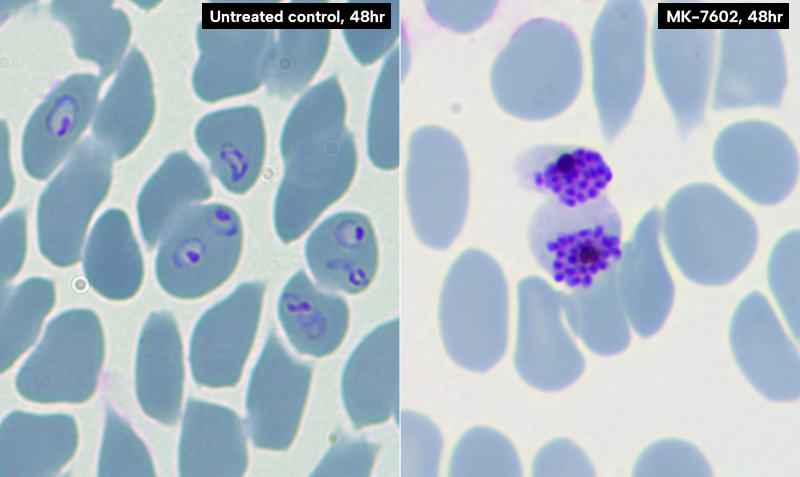

Working to advance the fight against malaria
The emergence of drug-resistant parasites has complicated efforts to control and eliminate malaria, which remains a leading cause of preventable illness and death globally, killing an estimated 600,000 people a year.
Children under 5 are the most vulnerable – it is estimated that a child dies of malaria every minute.
The new drug candidate MK-7602 targets the most prevalent malaria parasites in humans, Plasmodium falciparum and Plasmodium vivax, and blocks two essential parasite enzymes, providing a unique dual-action strategy with the potential to reduce the risk of resistance.